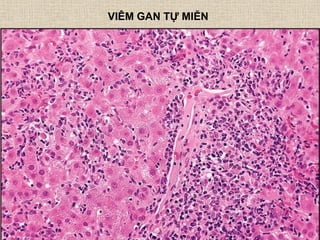
VIÊM GAN TỰ MIỄN
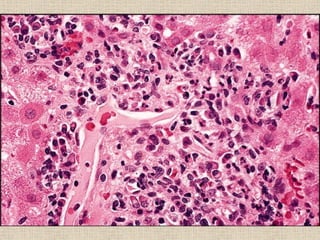

Tài liệu trình bày các loại bệnh lý gan, bao gồm viêm gan siêu vi, tổn thương gan do rượu, hóa chất, và các bệnh ký sinh trùng. Nó cũng đề cập đến chẩn đoán hình ảnh và xét nghiệm chức năng gan, cũng như các loại ung thư gan như carcinoma tế bào gan và carcinoma tuyến. Các bệnh này ảnh hưởng lớn đến sức khỏe gan và ngày càng trở nên quan trọng trong y học hiện đại.